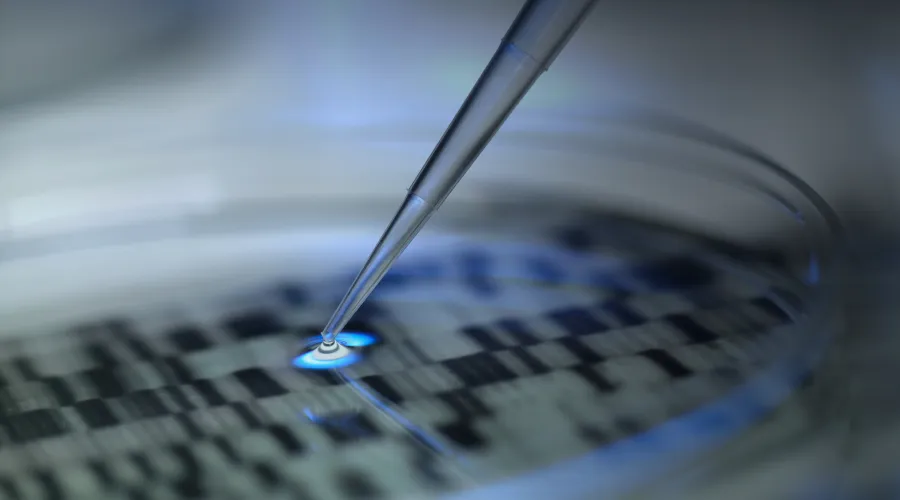

Research Initiatives
Clinical Scholar Pathway Program
The Clinical Scholar Pathway provides up to 20 percent protected time for an intensive, mentored research and career development experience for faculty who provide clinical care and are appointed in the department of internal medicine. The Clinical Scholar Pathway supports innovative, cutting-edge pursuits across all categories of internal medicine research.
The protected time will allow the clinical scholar to build and sustain a robust research program, participate in scientific service, submit new grants, and engage in professional development related to research. The program is competitive with an annual application and review process.
Clinician-Scientist Faculty Program
The Clinician-Scientist Faculty Program was designed to invest in the continued success and growth of our clinician-scientists. The program is a joint initiative from the College of Medicine and the department of internal medicine. The Clinician-Scientist Faculty Program establishes a framework for competitive, specialty-specific salary, dedicated effort toward research programs beyond what is extramurally funded, and a period of support when extramural funding decreases.
Applicants may request cost support for:
- The cost-share component of the extramurally funded effort
- Unfunded research effort
- Effort required and expected of extramurally funded researchers such as service or grant review committees, PhD committees, time to write new grant applications, and other professional development and service effort related to research and service/scholarship; generally limited to 10%
An initial application is required to be considered for the Clinician-Scientist Faculty Program. Annually, in conjunction with the fiscal year, a non-competing renewal will be required to update efforts/activities and confirm the commitment amount. Please discuss with your respective division chief.
Interested in Participating?
For additional information on the Clinical Scholar Pathway Program and the Clinical-Scientist Faculty Program, please contact IMResearch@uky.edu
Internal Medicine Research Symposiums

The Internal Medicine Research Day is hosted in conjunction with the Annual Center for Clinical and Translation Science (CCTS) Spring Conference. The Office of Research and Innovation in Internal Medicine (ORIM) supports the research symposium to highlight the impressive breadth and depth of research being conducted across all divisions. The event emphasizes the remarkable work happening at every level of science —from undergraduate students to senior faculty.
In 2025, the event featured over 50 post presentations and 7 invited oral presentations. ORIM is proud to support and promote the research led by the exceptional individuals within our department. Research Day provided an opportunity to celebrate accomplishments while continuing to grow research at the bench, at the bedside, and in the community.

Created by ORIM, The BIG DATA Workshop — Building Insights & Growth in Data Analytics, Technology, and Applications – is a new initiative aimed at advancing clinical and population health research using secondary data sources. The workshop is designed to enhance the research productivity and collaborative potential across the department’s 16 divisions. Experts in clinical research, epidemiology, biostatistics, and biomedical informatics lead sessions focused on turning research questions into actionable projects with real-world impact.
The recurring initiative, led by Dr. Justin Xavier Moore, Assistant Director for Population Science in Internal Medicine, provides didactic and interactive learning focusing on educating faculty and trainees on how to align their research interests with appropriate datasets and analytical approaches. The workshop is a powerful collaboration between the ORIM and the Biostatistics Consulting and Interdisciplinary Research Collaboration Lab (Biostat CIRCL).
For more information, please contact IMResearch@uky.edu